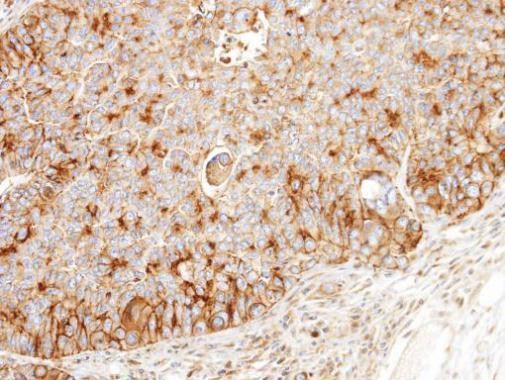
BCKDK Antibody in Immunohistochemistry (Paraffin) (IHC (P))

Search
Invitrogen
BCKDK Polyclonal Antibody
{{$productOrderCtrl.translations['antibody.pdp.commerceCard.promotion.promotions']}}
{{$productOrderCtrl.translations['antibody.pdp.commerceCard.promotion.viewpromo']}}
{{$productOrderCtrl.translations['antibody.pdp.commerceCard.promotion.promocode']}}: {{promo.promoCode}} {{promo.promoTitle}} {{promo.promoDescription}}. {{$productOrderCtrl.translations['antibody.pdp.commerceCard.promotion.learnmore']}}






Please note: We are reviewing Western blot images included in the antibody testing data in our catalog, including those provided by third parties. Unless expressly labeled or annotated as “raw-unedited”, Western blot images included in the antibody testing data in our catalog may have been edited, optimized or otherwise adjusted for presentation.
产品信息
PA5-28050
种属反应
宿主/亚型
分类
类型
抗原
偶联物
形式
浓度
规格
纯化类型
保存液
内含物
保存条件
运输条件
RRID
产品详细信息
Recommended positive controls: MCF-7, MCF-7 membrane extract, Mouse brain, rat brain, rat kidney.
Predicted reactivity: Mouse (99%), Rat (100%), Zebrafish (82%), Xenopus laevis (87%), Rhesus Monkey (98%), Bovine (98%).
Store product as a concentrated solution. Centrifuge briefly prior to opening the vial.
靶标信息
The second major step in the catabolism of the branched-chain amino acids, isoleucine, leucine, and valine, is irreversibly catalyzed by the branched-chain alpha-keto acid dehydrogenase complex (BCKD), an inner-mitochondrial enzyme complex composed of 3 catalytic components: a branched-chain alpha-keto acid decarboxylase (E1), a dihydrolipoyl transacylase (E2), and a dihydrolipoamide dehydrogenase (E3). The complex also contains 2 enzymes that regulated the state of activity of the BCKD complex: a kinase (BCKDK), and a phosphorylase. The ubiquitously expressed kinase contains 1 histidine kinase domain. Maple syrup urine disease (MSUD) is a pathology secondary to an enzyme defect in the catabolic pathway of leucine, isoleucine, and valine. Accumulation of these amino acids and their corresponding keto acids results in encephalopathy and progressive neurodegeneration in infants not treated for MSUD.
仅用于科研。不用于诊断过程。未经明确授权不得转售。
篇参考文献 (0)
生物信息学
蛋白别名: [3-methyl-2-oxobutanoate dehydrogenase [lipoamide]] kinase, mitochondrial; BCKD-kinase; BCKDH kinase; BCKDHKIN; Branched-chain alpha-ketoacid dehydrogenase kinase; EC 2.7.11.4
基因别名: AI327402; BCKDK
UniProt ID: (Rat) Q00972, (Mouse) O55028
Entrez Gene ID: (Rat) 29603, (Mouse) 12041